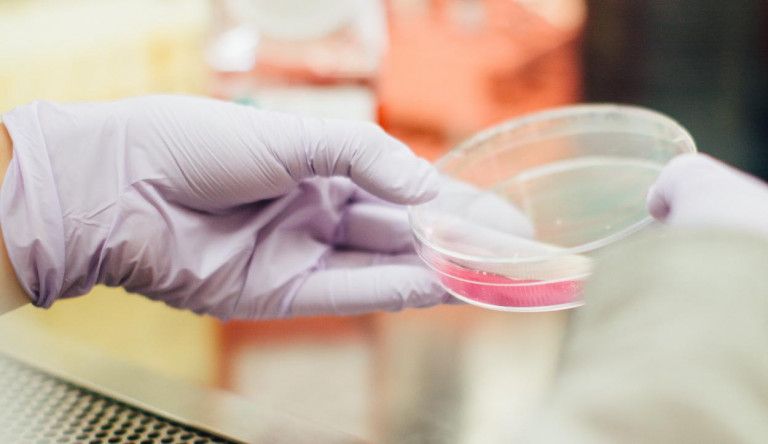
A krízis elérte a járványügyet: bezárt Veszprém megye mikrobiológiai laborja

Belpol
Závecz Research: Karácsony verheti Tarlóst
Van, aki szerint Kálmán Olgának nagyobb esélye lett volna, ha nyer az előválasztáson.
Két évet csúszhat a Nemzeti alaptanterv bevezetése
Amit azért kell átalakítani, mert a kormány szerint az első kidolgozott verzió nem sikerült elég nemzetire.
Az iparági átlagnál 80 milliárddal több extraprofitot halmoztak fel a NER vállalkozói
A nyereség nagy részét általában kivették a cégekből.
Akár 20%-kal többet kell idén fizetnünk, ha a Balatonon strandolnánk
Nagy strandbelépőkörképet csináltak: minden drágább.
A krízis elérte a járványügyet: bezárt Veszprém megye mikrobiológiai laborja
A labor kiesése veszélyeztetheti a helyi betegellátás biztonságát.
Megduplázódtak Schmidt Mária juttatásai, az alapítványába meg ötmilliárdnyi közpénzt öntöttek
Mindez történelmiesített propagandára ment.
Orbán vészjósló levelet írt a Néppárt elnökének, mi lesz, ha Timmermanst választják meg az Európai Bizottság elnökének
Mintha kissé kétségbe lenne esve a magyar miniszterelnök.
Felülvizsgálná a Kúria az óvadék kiszabásának gyakorlatát Viking Sigyn kapitányának ügye apropóján
A Kúria elnökhelyettese szerint a feltételes szabadságra bocsátásra is nagyobb figyelmet kell fordítani a jövőben, mert “automatizmussá kezd válni.”
Ki nyert itt?
Az eddigi legmagasabb részvétellel megtartott EP-választáson a Fidesz magasan nyert, de vezetői vasárnap este mégsem tűntek felhőtlenül boldognak. Az ellenzéknek viszont, noha országos támogatottsága nem javult látványosan, hosszú idő után van oka némi bizakodásra.